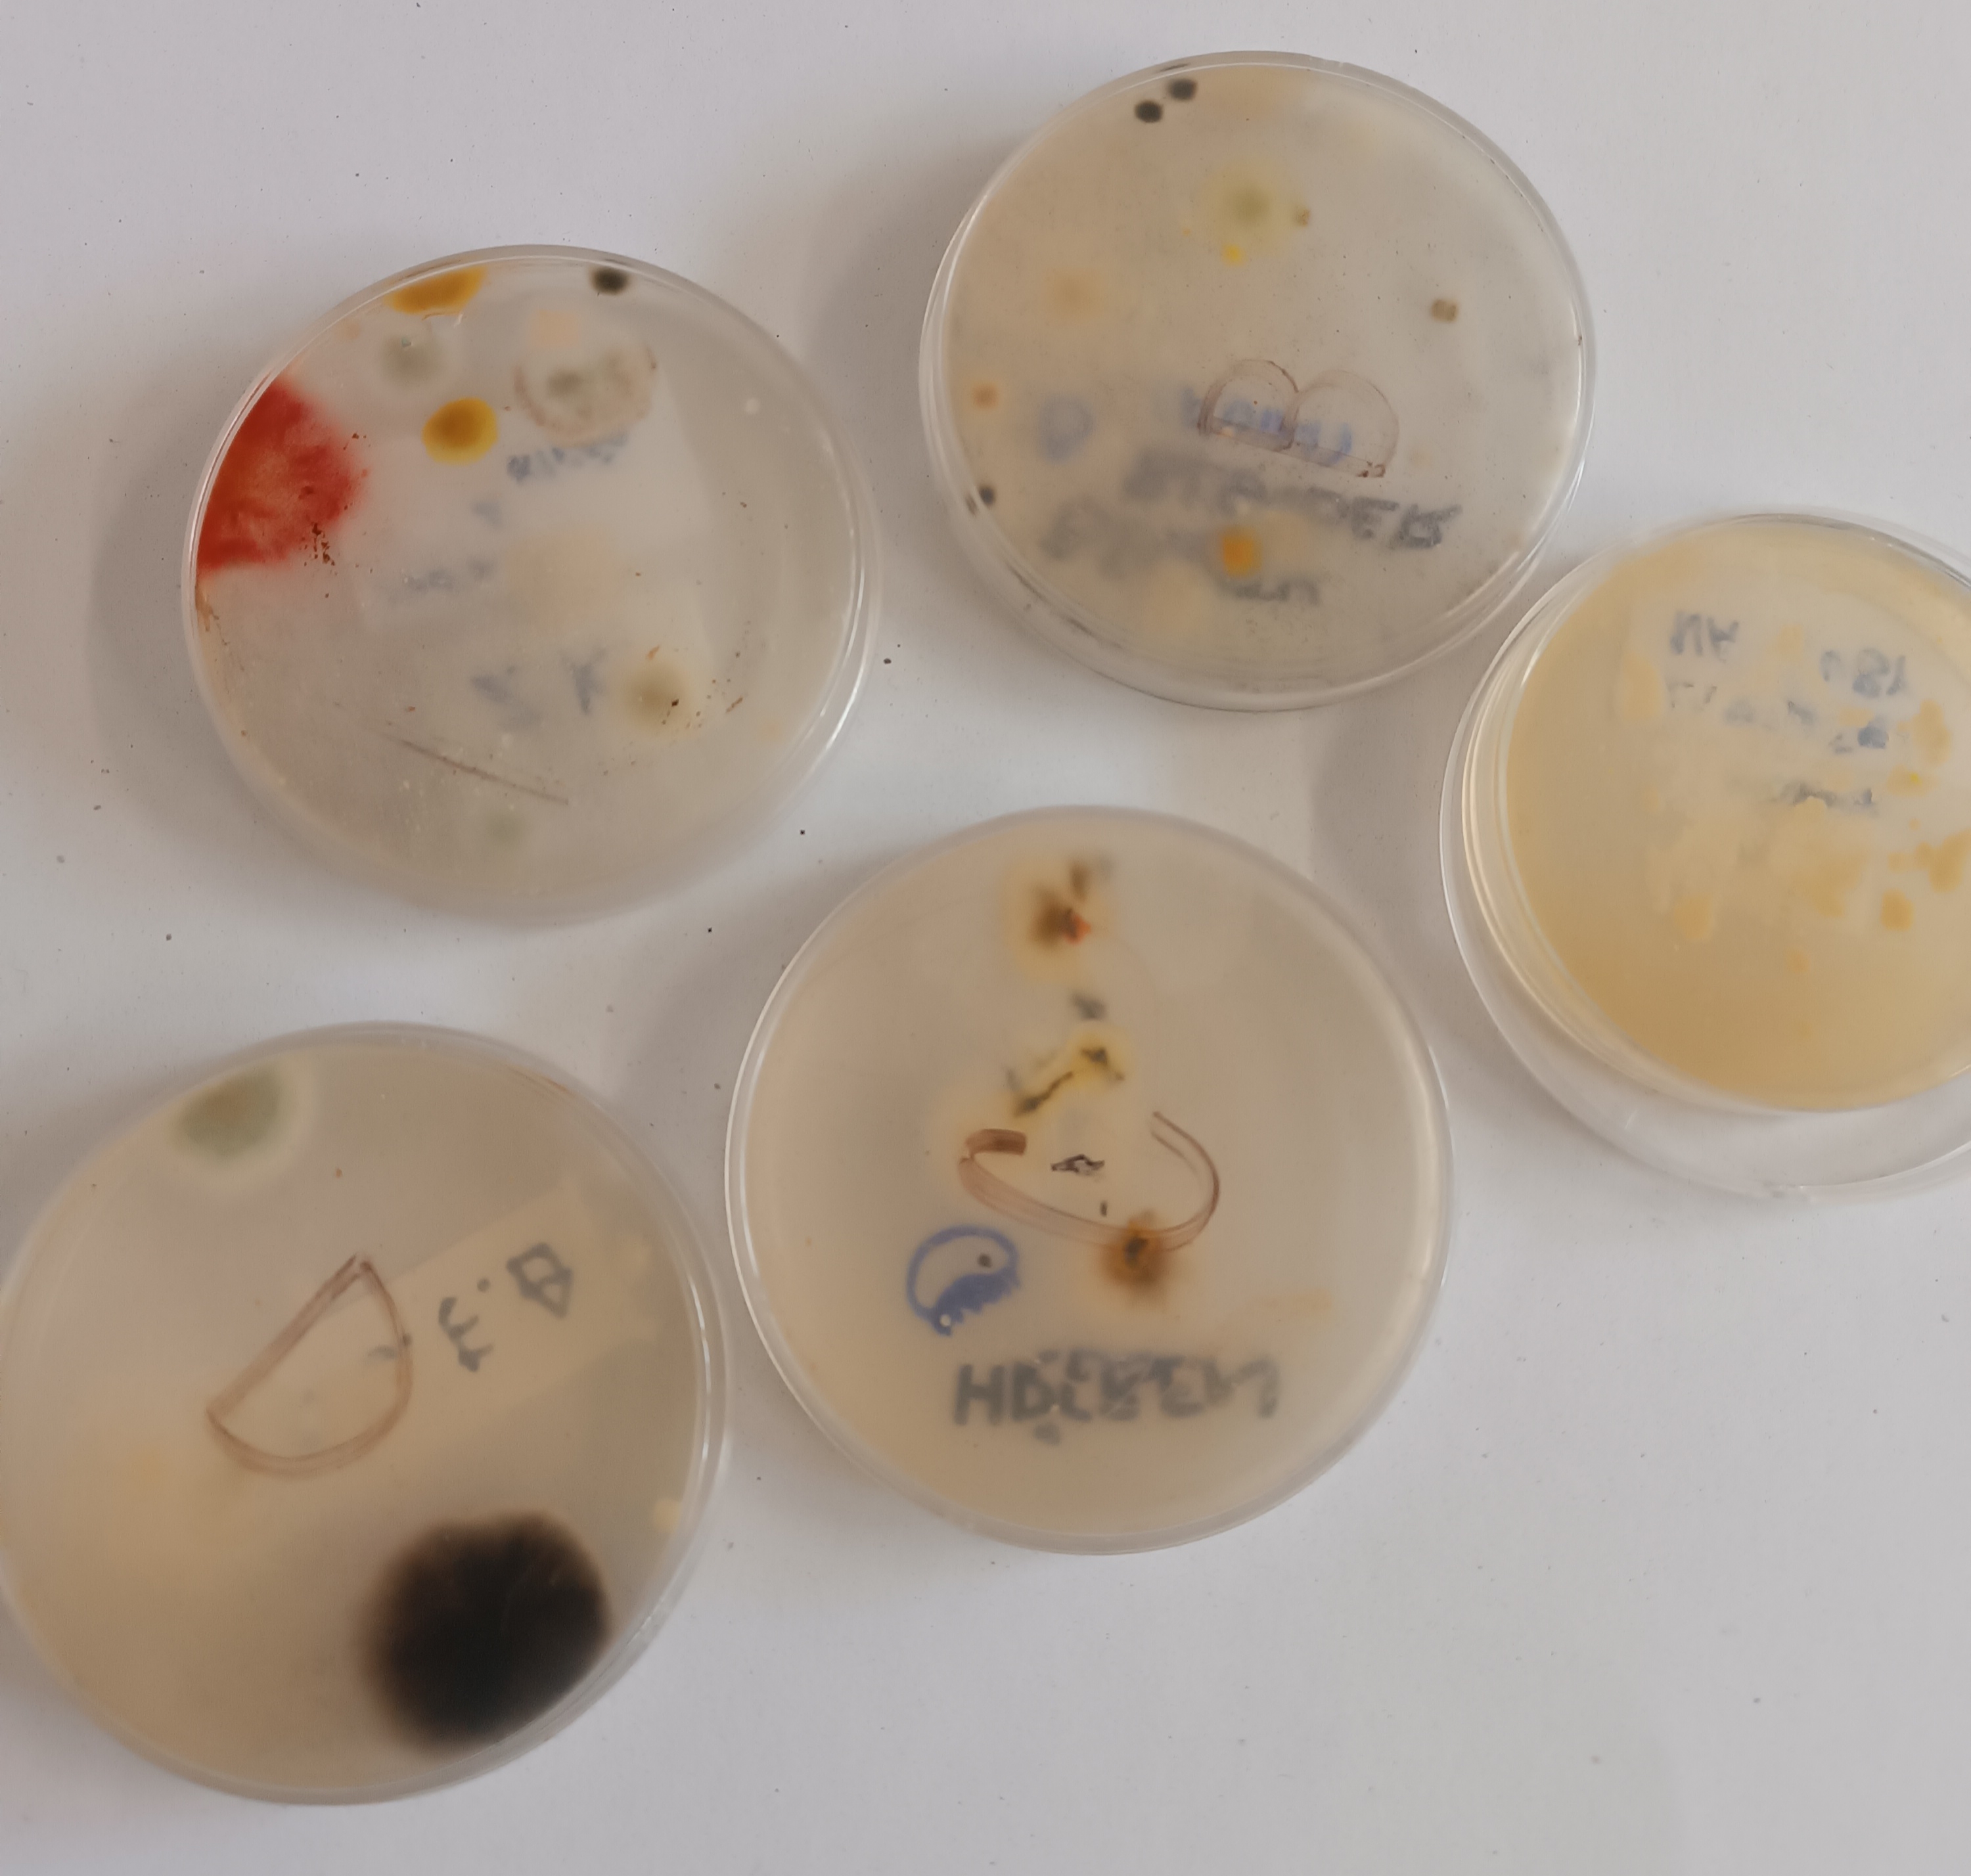
Misky

Bezplatné propojení učitele s dobrovolníkem.
Nadšení a zkušenosti z praxe ve výuce.
Vysvětlení tématu odborníkem a zapojení žáka jinak než učebnice.
Stačí si jen vybrat.
A tak jsme si vybrali. Žanetu Molišovou, odbornici na greenwashing, mikroplasty a tvůrkyni aplikace GreenScan a GreenGate.

Díky ní jsme se zamysleli, kolik chemických produktů denně používáme a zda je jejich složení pro naše tělo a přírodu v pořádku. Je možné takové výrobky nahradit přírodními produkty? A mají i ony svoje negativa?

Na praktickém workshopu jsme si vlastnoručně vyrobili deodorant, zubní pastu, pleťové sérum nebo parfém. Zjistili jsme, že to zvládne každý i bez chemické laboratoře a produktů z ropy.

Léčiva a doplňky stravy – kdy pomáhají a kdy je čas zpomalit. Bolí tě hlava? Někdy stačí voda, spánek… Pojďme se učit ptát „proč?“ dřív, než sáhneme po pilulce.

Bakterie a antibiotická rezistence je to problém? Co se ukrývá v našem zubním kartáčku, v hřebenu nebo kosmetickém štětečku? A je opravdu nutné neustále používat antibakteriální dezinfekci, nebo stačí prosté mýdlo?
S 1. B jsme stopy denně používaných předmětů otiskly do agaru na Petriho miskách a po několika dnech „obdivovali“ barevné kolonie mikroorganismů, bakterií a plísní.
Den pro školu nás přiměl zpomalit a zamyslet se, kdy může být chemie náš kamarád a pomocník a kdy je za kosmetickým výrobkem jen reklama a marketinkový trik.
Dagmar Muzikářová
